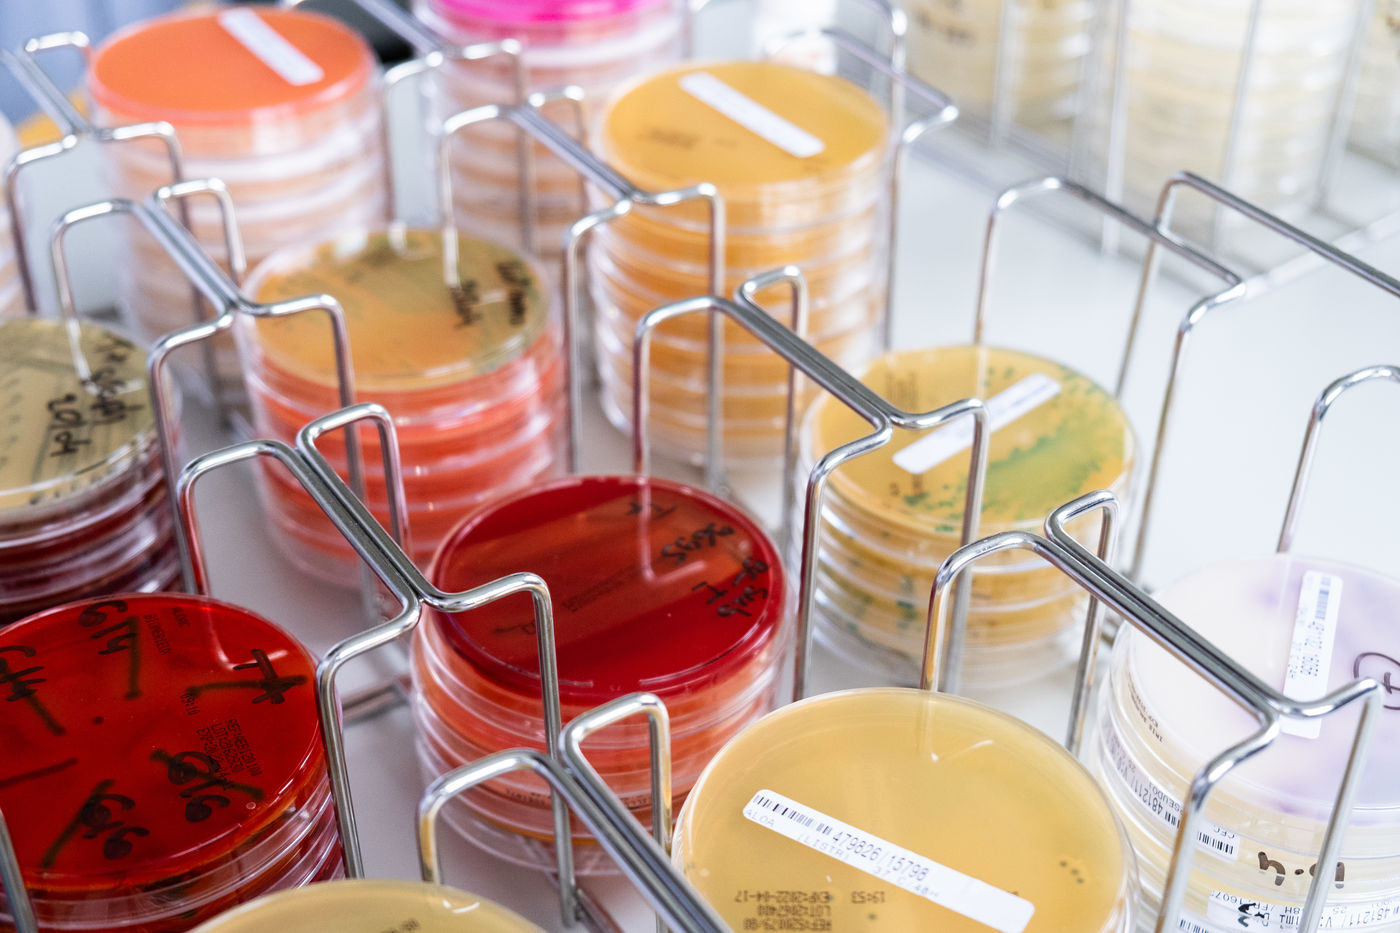

Pour accéder à la série en entier, vous devez vous logger ou demander un compte Hans Lucas en cliquant ici.
Sécurité alimentaire des cantines
Le laboratoire départemental EVA (Eau - Vétérinaire - Air) s'occupe de réaliser des prélèvements réguliers dans l'ensemble des cantines de collège du département pour les analyser ensuite et assurer la sécurité alimentaire des collègiens. Les analyses recherchent en particulier des traces de salmonelle, de listeria ou de Escherichia coli.
Canteen food safety
The EVA departmental laboratory (Water - Veterinary - Air) takes care of taking regular samples from all the secondary school canteens in the department to then analyze them and ensure the food safety of secondary school students. The analyzes look in particular for traces of salmonella, listeria or Escherichia coli.